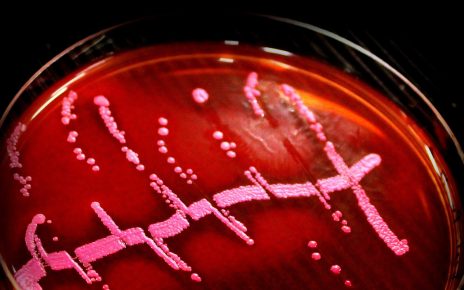

Istoria termenului „narcisist” pare la prima vedere limpede, aproape intuitivă, pentru că imaginea tânărului Narcis a rămas una dintre cele mai puternice metafore ale culturii europene. În mitul grec, băiatul care se îndrăgostește de propria reflecție într-un ochi de apă și moare fără să înțeleagă că imaginea îi aparține a fost folosit secole întregi ca avertisment împotriva vanității. Totuși, interesant este faptul că psihologia nu pornește de la mit, ci de la două definiții formulate într-un limbaj strict medical, fără legătură reală cu dimensiunea poetică a mitului antic.
Primul care a folosit cuvântul „narcisism” într-un sens tehnic a fost medicul și sexologul englez Havelock Ellis, în 1898. Ellis era un cercetător fascinant, greu de încadrat în tiparele științei victoriene, preocupat de comportamentele sexuale atipice și de zonele în care corpul și psihicul se întâlneau fără reguli. Într-un studiu despre „autoerotism”, el a descris narcisismul ca pe o formă extremă de auto-orientare erotică, un comportament în care individul își transformă propriul corp în obiect de dorință. Era o idee radicală pentru epocă, nu doar pentru că sfida normele morale ale sfârșitului de secol XIX, ci pentru că muta discuția despre sexualitate în zona psihologiei profunde, acolo unde dorințele nu mai erau explicate prin păcat sau degenerescență, ci prin dinamici interne încă insuficient înțelese.
Un an mai târziu, în 1899, psihiatrul german Paul Näcke a folosit independent același termen, dar cu o nuanță diferită. Näcke era unul dintre reformatorii psihiatriei germane, preocupat de clasificări riguroase și de standardizarea limbajului clinic. Pentru el, narcisismul nu era o abatere morală, ci o tulburare de percepție și raportare la sine, în care individul confunda obiectul iubirii cu propria identitate fizică. Näcke a introdus termenul în discursul medical cu aceeași precizie cu care descria melancolia sau paranoia, contribuind fără să știe la ceea ce avea să devină unul dintre conceptele centrale ale psihologiei secolului XX.
Dar adevărata popularizare a termenului a venit odată cu Sigmund Freud. În 1914, acesta a publicat studiul „On Narcissism: An Introduction”, în care a făcut pasul decisiv: a scos narcisismul din zona strict sexuală și l-a transformat într-o piesă fundamentală a dezvoltării psihice. Freud a susținut că un copil trece în mod firesc printr-o etapă de auto-investire afectivă, un moment în care lumea nu este încă separată de sine, iar stima de sine funcționează ca un mecanism de supraviețuire. Doar atunci când această etapă rămâne fixată, sau când este reactivată în mod exagerat în viața adultă, apare ceea ce el numea „narcisism secundar”, o formă de retragere a libidoului din relații și plasarea lui înapoi pe sine. Această idee a schimbat radical modul în care psihologia privește personalitatea. Narcisismul a încetat să mai fie o curiozitate erotică, devenind un concept-cheie în explicarea ego-ului, a vulnerabilității și a modului în care oamenii formează atașamente.
Pe măsură ce psihanaliza s-a dilatat în spațiul public, termenul a început să capete sensuri mult mai largi. În a doua jumătate a secolului XX, teoreticieni precum Heinz Kohut și Otto Kernberg au dus discuția într-o direcție complet nouă. Kohut, fondatorul psihologiei sinelui, a arătat că narcisismul nu este doar o problemă, ci și expresia unei nevoi fundamentale de validare, o componentă a dezvoltării sănătoase a identității. Kernberg, în schimb, a analizat narcisismul patologic din perspectiva relațiilor interpersonale, subliniind tendințele de exploatare și lipsa empatiei. Amândoi au influențat decisiv criteriile actuale din Diagnostic and Statistical Manual of Mental Disorders (DSM-5), unde tulburarea narcisică de personalitate este definită printr-un amestec de grandiozitate, nevoi constante de admirație și dificultăți profunde în a relaționa autentic.
Astăzi, cuvântul „narcisist” circulă în conversațiile cotidiene cu o ușurință pe care nici Ellis, nici Näcke și nici Freud nu și-ar fi imaginat-o. Psihologii contemporani atrag atenția că termenul este adesea folosit incorect, într-un mod care banalizează o noțiune complexă. Conform CNN, psihoterapeuții americani au observat o creștere accentuată a folosirii populare a cuvântului, în special pe rețelele sociale, unde este aplicat rapid oricărui comportament perceput drept egoist sau rece. În realitate, narcisismul este un spectru, iar majoritatea oamenilor manifestă trăsături narcisice firești, esențiale pentru stima de sine și pentru capacitatea de a-și susține identitatea în fața lumii.
Povestea termenului „narcisist” este, de fapt, o poveste despre felul în care știința reușește să transforme un mit într-un instrument de înțelegere a psihicului. De la un concept medical rigid, folosit la început pentru a denumi comportamente autoerotice, până la unul dintre cele mai discutate fenomene psihologice contemporane, narcisismul a trecut prin reinterpretări succesive care i-au lărgit sensurile și i-au dat o actualitate surprinzătoare. În această evoluție se vede cum psihologia modernă nu doar descrie comportamente, ci reușește să reconfigureze felul în care oamenii își privesc propria identitate, propriile dorințe și zonele fragile ale sinelui.
Surse:
https://www.britannica.com/biography/Havelock-Ellis
https://link.springer.com/rwe/10.1007/978-3-319-28099-8_1293-1
https://pmc.ncbi.nlm.nih.gov/articles/PMC12645804/
Vă mai recomandăm să citiți și:
Psihologia infidelității: De ce înșală oamenii și ce se întâmplă în cuplu după o trădare?
Ce spun psihologii despre copiii care numără pe degete?
Articolul Cum a devenit „narcisismul” unul dintre cele mai folosite cuvinte ale psihologiei modern apare prima dată în Descopera.
Această știre a fost preluată de pe portalul amintit
Această informație preluată de pe portalul mai sus amintit, nu reprezintă o informație oficială a unei autorități, însă în latura de știre prezintă o informație veridică. potrivit legii 8/1996 știrile pot fi preluate chiar de la un portal la altul, nefiind opere sau lucrări ce necesită drept de autor, însă din spirit deontologic oferim sursa acestora.
Leontiuc Marius – senior editor
Împotriva articolelor redacției noastre, persoanele nemulțumite pot formula Contestație în termen de 10 zile de la publicarea articolului, la judecătoria Orășenească nr. 1 München Bayern Deutschland, in conformitate cu Legea federală Germană. Considerăm că nu se pot formula acțiuni la instanțele din România deoarece nici o persoană care activează în trustul nostru nu poate fi extrasă de sub jurisdicția federală germană. Considerăm că redacția noastră nu răspunde în fața autorităților din România ci doar celor federale sau civile germane. deoarece legea română nu are efecte de extraneitate asupra redacției chiar dacă subiectul știrilor face obiectul unor evenimente sau persoane din România și sunt scrise în limba română. Limba română nu este izvor de extraneitate a legii.